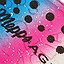
цвет RBT

Aglia, Mepps

| Название | Размер | Вес | |
| B0 (BKYR) | 0 | 2.5 гр |
|
| B1 (BKYR) | 1 | 3.5 гр |
|
| B2 (BKYR) | 2 | 4.5 гр |
|
| B3 (BKYR) | 3 | 6.5 гр |
|
| B4 (BKYR) | 4 | 9 гр |
|
| B5 (BKYR) | 5 | 13 гр |
|
Размещено 26.11.2015 пользователем ivstig
Для рыбы: окунь, хариус, щука
Достоинства:
Отличное качество.
Недостатки:
Не обнаружено
Общие впечатления:
Любимые мои вертушки. Проверял на окуне, щуке (река Томь) и на хариусе (река Ушайка), Томская обл. Я обладаю двумя блеснами Agglia Meps. На модельку B3 (C) 6,5 г. неплохо ловятся окуньки и щуки на Томи и на разных озерах Томской области. Модель B2 (RBT) весом 4,5 г специально брал, чтоб поймать хариуса на р.Ушайка. Хариуса там мало. Он там иногда абсолютно случайно берется на ручейника и червя. Но я задумал опробовать именно эту блесенку, и был удивлен, когда мне часов за 5 удалось из Ушайки выловить на нее двух маленьких хариусов. Считаю это очень недурным результатом, если учесть превратности ловли хариуса именно в этом водоеме. Значит блесна работает.

Общие впечатления:
К блесне mepps aglia 2 питаю самые нежные чувства. Без рыбы она не оставляла меня ни разу! Мне всегда казалось, что мелкие вертушки подходят сугубо для мелких окуней, но моя практика использования этой блесны показала другое. Именно на эту маленькую блесенку был установлен мой щучий рекорд 3 кг. Да и все последующие особи были не менее килограмма.
Блесна приспособлена для ловли на глубине около 1 метра, бросала в берег, выманивая щук из тростника и прибрежных коряг. Повторюсь, что это единственная вертушка, на которую у меня всегда брала крупная щука! Пробовала блесну на глубине больше 2,5-3 м ждала пока утонет и медленной проводкой протаскивала наверх, но при такой ловле результата не было. Мой опыт подсказывает, что это приманка для взрослых особей. По качеству фурнитуры претензий нет. В моей коллекции есть медная, золотая и серебрянные Aglia, но медная однозначно фаворит. Хотя и другие блесны этой же формы тоже весьма уловистые. Еще, что особо важно, блесну видно практически в любой воде, даже в очень мутной.

| Название | Количество приманок |
| Блесны ультралайт | 26 |
| Приманки ультралайт | 94 |
| Текущее место | - |
|---|---|
| Лучшее место | 6 |
| Худшее место | 20 |
| Длительность участия в днях | 3269 |
| Среднее значение места | 9.789473684210526 |
